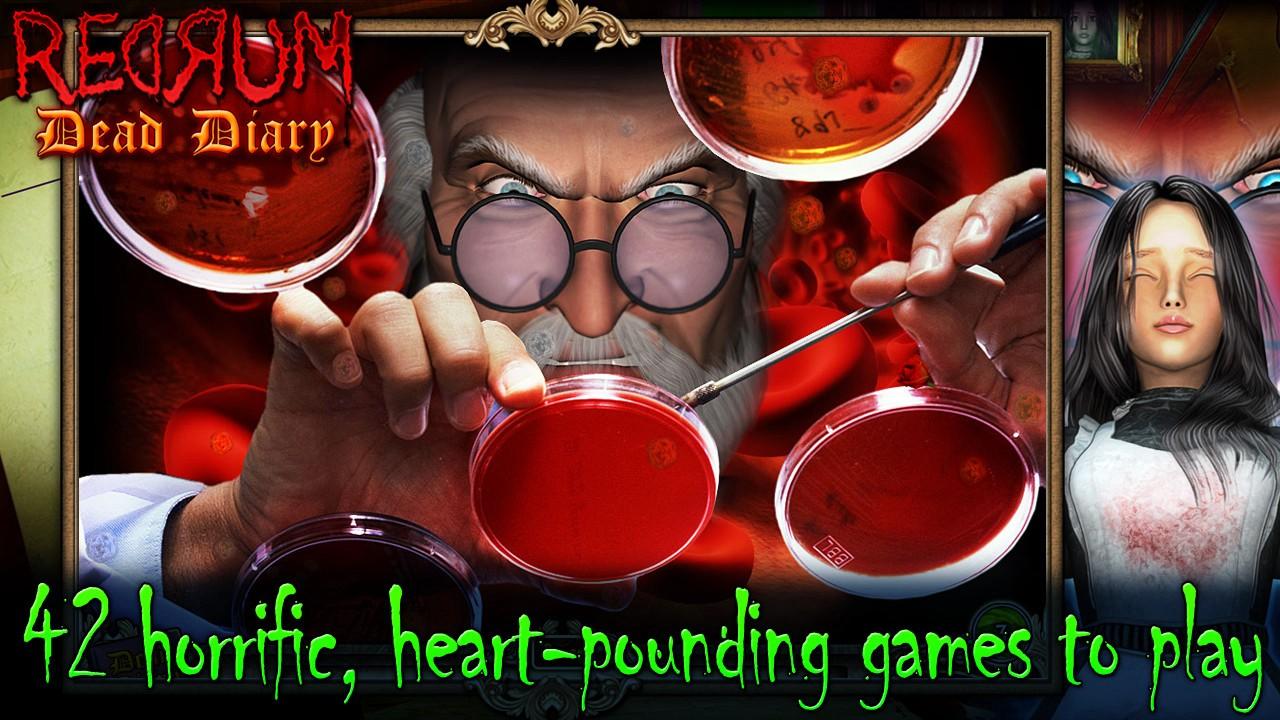
Screenshot 7

Red Dead Redemption, Red Alert, Red Faction и другие Red игры на Гейминг Гудс по лучшей цене. Вестерны, стратегии и шутеры. Steam-ключ, мгновенная доставка.
Redrum: Dead Diary Steam Ключ
О товаре
Роуз видит мертвых людей, которые были убиты несправедливо, и их смертные желания остаются невыполненными. Ее сверхпрактичный отец отказывается верить ее призрачным видениям и помещает ее в убежище, где она попадает в лапы злого доктора Зигмунда Мошенника.
Помогите Роуз использовать свои экстрасенсорные способности, чтобы раскрыть ужасные убийства и перехитрить маньяка-убийцу в этой пугающей для позвоночника тайне. Ужасные, душераздирающие игры, чтобы играть в ужасные убийства в семи главах Впечатляющая графика и преследующая музыка Используйте психические силы, чтобы перехитрить маньяка-убийцу Помогите Розе избежать цепей злого доктора Мошенничества
Инструкция по активации
Перейдите на: http://store.steampowered.com/ и скачайте клиент STEAM. Нажмите «Install Steam» (в правом верхнем углу). Установите и запустите приложение, войдите, используя имя учетной записи и пароль (создайте их, если у вас их нет). Пожалуйста, следуйте этим инструкциям для активации новой покупки в Steam: Запустите Steam и войдите в свою учетную запись Steam. Нажмите меню «Игры». Выберите «Активировать продукт в Steam...». Следуйте инструкциям на экране для завершения процесса. После успешной проверки кода перейдите на вкладку «МОИ ИГРЫ» и начните загрузку.
FAQ
Как активировать?
Работает ли из России?
Когда получу ключ после оплаты?
REDRUM — ключ для активации
Похожие товары
SteamRedrum Набор Steam Ключ
SteamEdward's Journey Steam Ключ
SteamCountryballs: Over The World Steam Ключ
Xbox OneManeater XBOX One / Xbox Series X|S Online Аккаунт Activation
X Rebirth Complete Steam Ключ
Sky Break Steam Ключ
SteamWhimside PC Steam Ключ
Xbox One